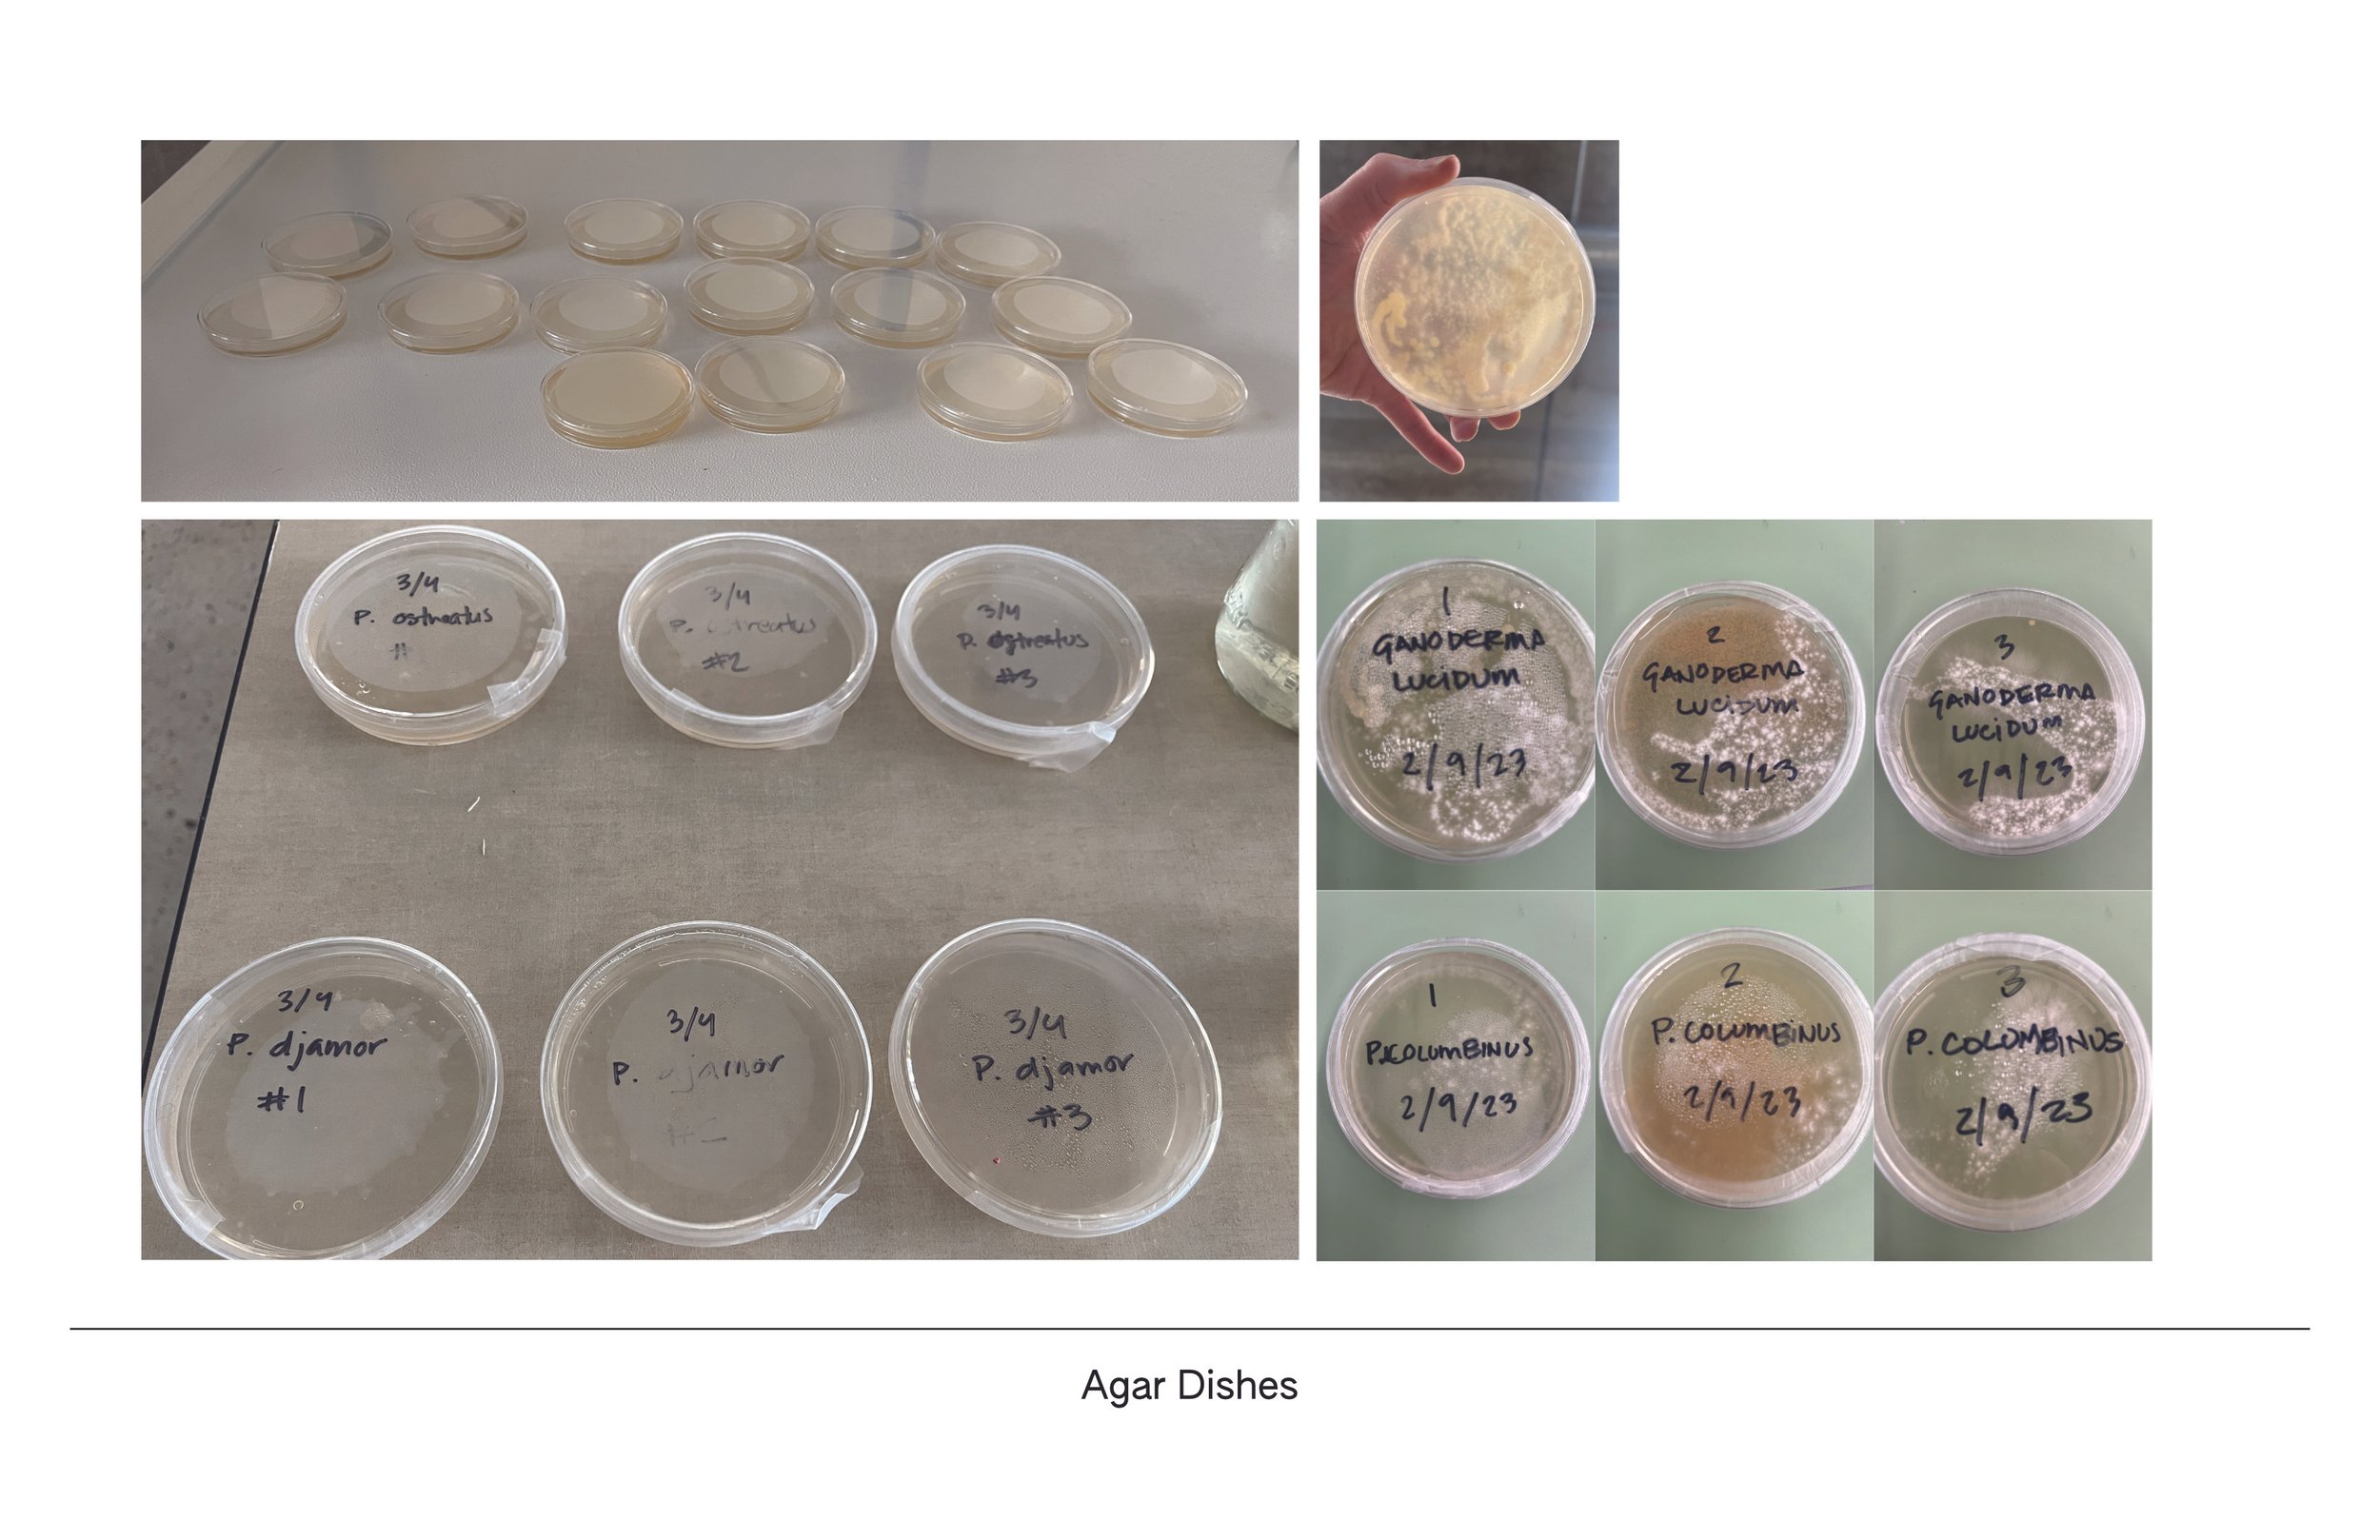
ErinWalrath_Presentation_9.jpg

BioDesign
This research supports the development of the Fun Wall product in Studio VI. The experiment compares and analyzes different fungal species and growth conditions to evaluate their ability to break down polyethylene terephthalate (PET) and polyurethane (PU) plastics. While the results showed some promising trends, further research is needed.